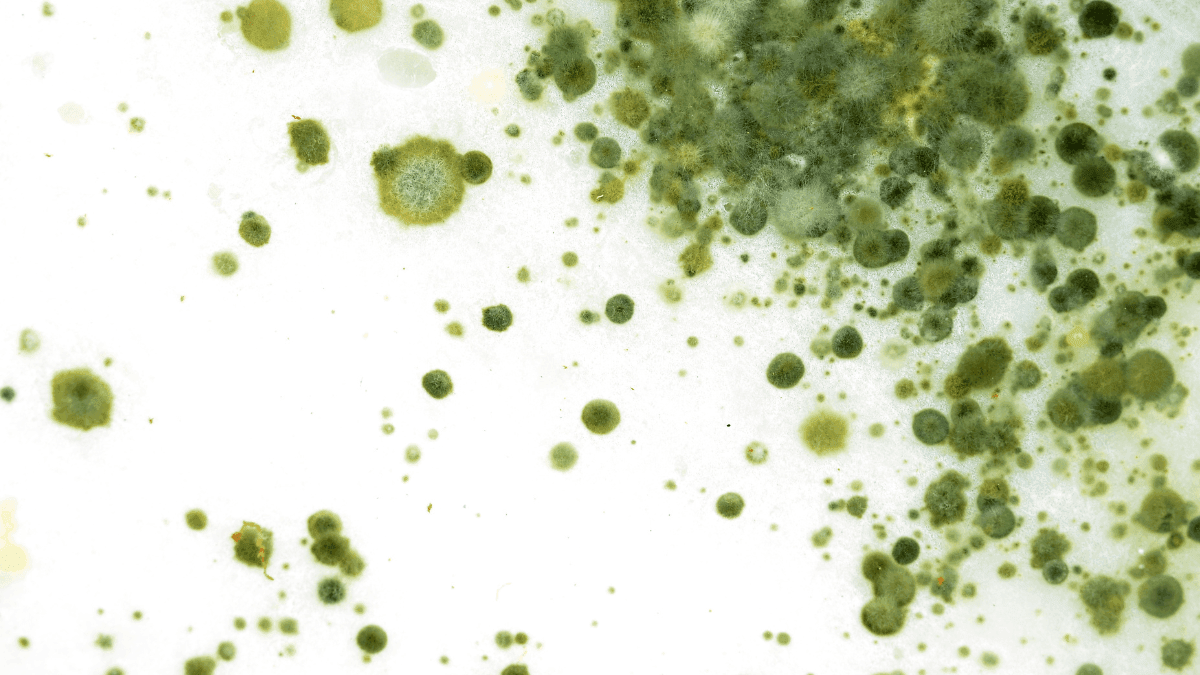
Fungo isolado da Cannabis sativa apresenta potencial antibacteriano e antioxidante, aponta estudo

Fungo da cannabis revela potencial antibacteriano e antioxidante
Pesquisa publicada na Natural Product Research revela potencial farmacêutico de fungo isolado da Cannabis sativa
Publicada em 20/02/2026

Fungo presente nas folhas da Cannabis sativa pode ser fonte de novos agentes antibacterianos | CanvaPro (Foto Ilustrativa)
O fungo endofítico da cannabis Chaetomium globosum EFY14, isolado de folhas de Cannabis sativa, demonstrou atividade antioxidante e ação antibacteriana contra microrganismos como Escherichia coli e Staphylococcus aureus, segundo estudo publicado na revista científica Natural Product Research.
A pesquisa, intitulada Evaluation of the antibacterial and antioxidant potential of the endophytic fungus EFY14 from Cannabis sativa L. leaves, amplia o campo da biotecnologia da cannabis ao explorar não apenas seus fitocanabinoides, mas também o microbioma associado à planta.
Metabolômica e modelagem molecular
O EFY14 foi isolado de folhas de Cannabis sativa L. e identificado taxonomicamente como pertencente ao gênero Chaetomium. Para caracterizar seu perfil químico, os pesquisadores aplicaram metabolômica não direcionada, técnica que permite mapear centenas de metabólitos simultaneamente.
A análise revelou:
- 20,823 ± 1,449 mg/L de compostos fenólicos totais (equivalente a ácido gálico)
- 0,230 ± 0,007 mg/mL de flavonoides totais (equivalente a rutina)
Entre os compostos identificados estão flavonoides e fenólicos bioativos como 4',7-dihydroxy-8-methylisoflavone, escopoletina, xanthohumol, tricina, sophoraflavanone G, prenil glicosídeo, melilotosídeo e maltol. A análise também detectou ácido canabidiológico (CBDA).
Para investigar possíveis mecanismos de ação, os autores utilizaram molecular docking e simulações de dinâmica molecular, prevendo interações estáveis entre os metabólitos e potenciais alvos biológicos relacionados a processos oxidativos e bacterianos.
Atividade antioxidante e antibacteriana
Nos ensaios laboratoriais, o extrato apresentou capacidade de eliminação de radicais livres pelo método DPPH, indicando atividade antioxidante relevante.
Além disso, demonstrou atividade antibacteriana contra:
- Escherichia coli
- Bacillus subtilis
- Staphylococcus aureus
Esses microrganismos estão associados a infecções humanas e contaminações alimentares, o que amplia o interesse industrial e farmacêutico do achado.
Cannabis além dos canabinoides
O estudo reforça um ponto estratégico para a ciência da cannabis: o potencial biotecnológico do seu microbioma endofítico. Fungos associados a plantas medicinais já demonstraram capacidade de produzir moléculas de alto valor terapêutico — como ocorreu historicamente com o taxol isolado de fungos endofíticos ligados a Taxus.
No caso da cannabis, os resultados sugerem que microrganismos simbióticos podem atuar como fontes alternativas de compostos bioativos, inclusive com implicações futuras para síntese de canabinoides e desenvolvimento de bioinsumos agrícolas.
Os autores ressaltam, no entanto, que os achados são pré-clínicos e laboratoriais, exigindo validação em modelos in vivo e estudos de segurança antes de qualquer aplicação terapêutica.
Ainda assim, a descoberta amplia a fronteira científica da cannabis, deslocando o foco exclusivo dos fitocanabinoides para um ecossistema químico muito mais complexo — e promissor.